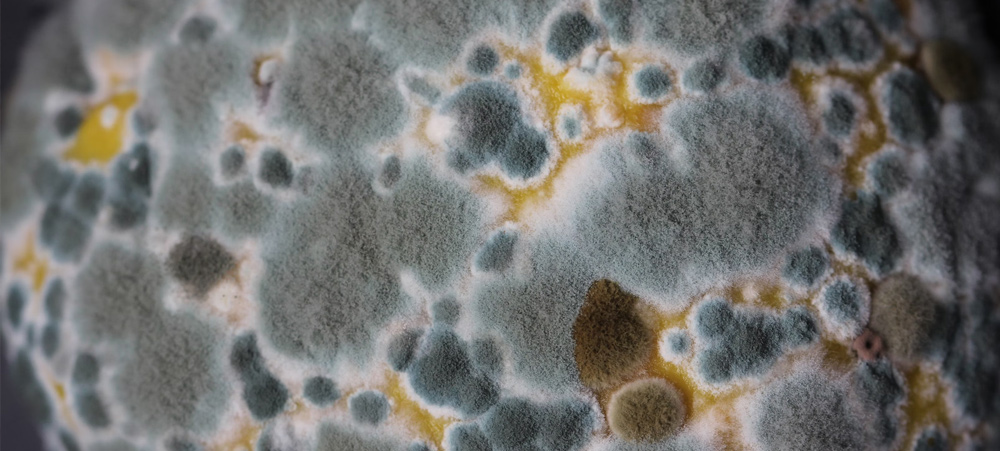

by Sunshine Urbaniak | Dec 20, 2022 | General Health
BLOG How Mold Affects Your Nervous System and Body The rain has been great for Sonoma County. The rainy season and winter are times when more mold is present. Watch this video of the symptoms of mold and mold toxins. There are both mental and physical issues with mold...

by Sunshine Urbaniak | Dec 13, 2022 | Allergies/Sensitivities, General Health
BLOG Resolving Cases of Hives and Other Skin Reactions Over the years, we have helped many patients resolve their reactive skin issues. Computer Person Reacting to Plastic One of the most dramatic cases was a computer person reacting to plastics. He would constantly...

by Sunshine Urbaniak | Dec 6, 2022 | Allergies/Sensitivities, Cravings/Dependency
BLOG Tired of Avoiding Food Sensivities? Does living with food sensitivities look like this? Feeling bad when eating the reactive foods Having food cravings Bloating and weight gain Constant digestive issues, fatigue, & brain fog Not sure what foods are causing a...

Recent Comments